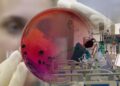
Салғырттық сан соқтырады

Қаскелеңде көптен күткен өнер мектебі ашылды. Бұрындары «ДОСААФ» иелігінде болған ғимарат Қарасай ауданы әкімінің араласуымен мемлекет меншігіне қайтарылып, күрделі жөндеуден өткізілді. Салтанатты шараға облыстық құрылыс басқармасының басшысы Мұхамедғаріп Құрманғалиев, Қарасай ауданының әкімі Жасұлан Естенов, білім беру саласының ардагерлері және қоғамдық ұйым өкілдері қатысты.
Қарасайлықтарды осы маңызды оқиғамен құттықтаған аудан әкімі Жасұлан Естенов пен білім бөлімінің басшысы Әсел Еркімбаева ең алдымен құрылысшылардың еңбегін атап өтті. Салтанатты шарада ол «Дәулет-Серпін ПМК 603» ЖШС мердігер ұйымының бірнеше өкіліне Алғыс хат табыс етті.
Өз кезегінде сөз алған Мұхамедғаріп Ниязұлы өткен жыл Қарасай ауданының білім саласы үшін өте сәтті болғанын, өйткені «Жайлы мектеп» ұлттық жобасы аясында алты жаңа оқу ордасы пайдалануға берілгенін атап өтті. Ал биыл Бұлақты және Алмалыбақ ауылдарында осындай білім шаңырақтарын ашу жоспарлануда.
Салтанатты шарада өнер мектебінің жаңартылған ғимаратының символикалық кілті мектеп басшылығына табыс етілді. Лентаны қиғаннан кейін қуанышты көруге келген қонақтар өнер мектебінің ішін аралап, мұндағы атқарылған жұмыстармен танысты. Экскурсия аяқтала берісімен жаңа мектептің тарихындағы алғашқы концерт қойылды.
1977 жылы салынған ғимарат күрделі жөндеуден өткеннен кейін өмірге қайта келгендей әсер қалдырады. Енді ол көптеген жас өскінге таланттарын шыңдауға көмектесетіні сөзсіз.
Айта кетерлігі, өнер мектебінде 530 баланың қосымша білім алуға мүмкіндігі бар, олар алдын ала конкурстық іріктеуден өткеннен кейін қабылданатын болады. Жас жеткіншектерге 64 педагог өнердің нәрін сіңіреді. Оқу бағдарламасы 17 бағытты қамтиды. Бұл қатарда домбыра, шертпе, қылқобыз, сырнай, ән-терме, пианино, гитара, саксофон, дәстүрлі ән, халық әні және цирк өнері сабақтары бар. Оқушыларды мұнда жас топтарына қарай бөлу жоспарлануда, бұл әр пәнді жақсы меңгеруге көмектеседі. Сондай-ақ бес жыл оқығаннан кейін түлектерге мемлекеттік үлгідегі куәлік беріледі.
Осыдан кейін аудандық Мәдениет үйінде «Мамандарға мың алғыс» атты мерекелік шара өтті. Бұл іс-шара Алғыс айту күні мен Жұмысшы мамандықтары жылына орай ұйымдастырылды. Шара барысында аудан әкімі Жасұлан Тоққожаұлы бірқатар еңбек адамына Алғыс хат табыстады.
Мерекеге орай өнер мектебінің фойесінде қолөнер көрмесі ұйымдастырылып, залда ересектер мен балалардың қатысуымен қызықты концерттік бағдарлама дайындалды. Бұл бағдарлама еңбек адамдары туралы театрландырылған қойылыммен басталып, әрбір концерттік нөмір шахтер, электрик, жүргізуші, диқан және басқа да жұмысшы мамандарға арналды.
Қуат ҚАЙРАНБАЕВ
Қарасай ауданы